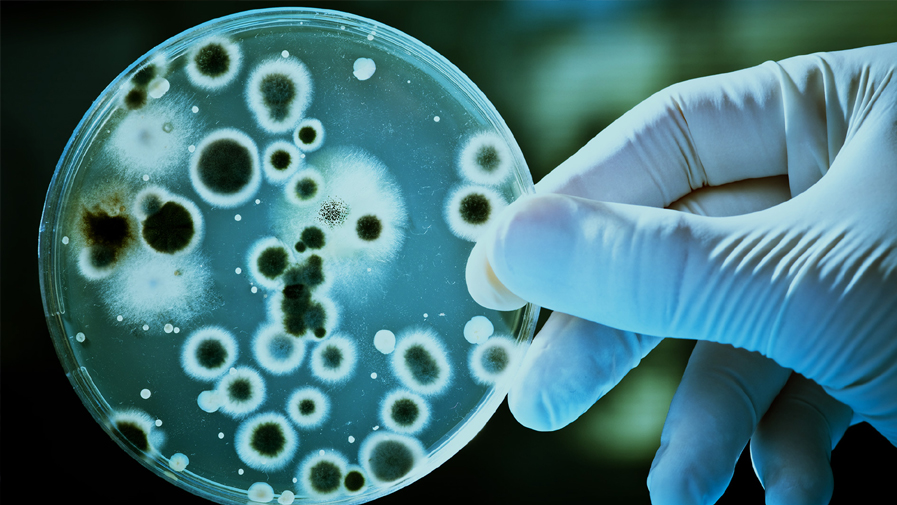
blog_img1

BS Bioinformatics & Biotechnology
The vision of the Bioinformatics & Biotechnology department is to prepare individuals who are excelled in practical techniques and theories of Bioinformatics & Biological databases that lead them on the way to become problem solving professionals.